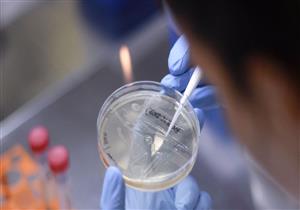
لقاحان روسي وبريطاني وصيني بالطريق.. هل ينتهي رعب كورونا في سبتمبر؟

إعلان
-
26 أكتوبر, 2020
-
21 أكتوبر, 2020
-
22 سبتمبر, 2020
-
12 سبتمبر, 2020
-
19 أغسطس, 2020
-
21 يوليو, 2020
-
29 يونيو, 2020
إعلان
إعلان